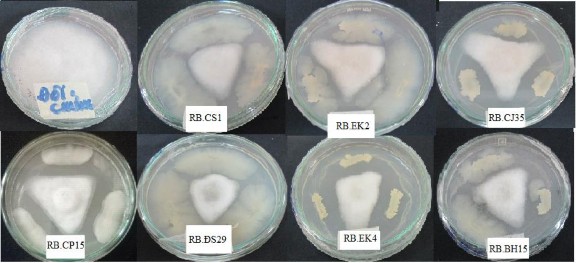
Hình 3 1 Khả năng kháng Phytophthora của một số chủng vi khuẩn sau 7 ngày Từ 269 2

nâu sẫm, có khối lượng 120 mg; (1) Cao chloroform (1): Dạng sệt, màu nâu sẫm, có khối lượng 760 mg; (3) Cao ethyl acetate (2): Dạng sệt, màu nâu đen, có khối lượng 1,02 g; (4) Cao ethyl acetate: methanol (90:10) (3): Dạng sệt, màu nâu đen, có khối lượng 3,10g; (5) Cao ethyl acetate: methanol (60 :40) (4): Dạng sệt, màu nâu đen, có khối lượng 15,2g; (6) Cao methanol (5): Dạng sệt, màu nâu đen, có khối lượng 22,6 gam; (7) Cao nước còn lại (6): Dạng rắn, màu vàng nâu, có khối lượng 156 gam.
Cao chiết thô được sử dụng để đánh giá hoạt tính kháng tuyến trùng trong điều kiện in vitro. Các cao chiết thô có hoạt tính kháng cao, khối lượng nhiều, có vệt trên sắc ký lớp mỏng tròn, rõ có khả năng tách tốt được sử dụng để phân tách hợp chất kháng bao gồm: Cao ethyl acetate: methanol (90:10) (3), chloroform (1) và ethyl acetate (2).
* Cao ethyl acetate: methanol (90:10) (3)
![]()
Hình 2.3. Quy trình phân tách các hợp chất VK01, VK02, VK03 và VK05
Thực hiện sắc ký cột silica gel pha thuận trên cao (3) (3,10 g) ban đầu với hệ dung môi C: Me = 90:10 rồi tăng dần độ phân cực đến hệ dung môi C: Me = 50:50 và sau cùng là Me. Dung dịch giải ly được hứng vào các lọ 50 ml, thực hiện SKLM các lọ và những lọ giống nhau được gom chung lại, cô quay thu hồi dung môi thu
được các phân đoạn. Kết quả là sắc ký cột trên cao (3) thu được 5 phân đoạn được ký hiệu từ (3).1 đến (3).5 (51,1 mg, 437,4 mg, 310,0 mg, 112,5 mg, 1,93 g).
Phân đoạn (3).2: Phân đoạn (3).2 (437,4 mg) được tiến hành sắc ký cột silica gel pha thuận, giải ly với hệ dung môi C: Me = 95:5 rồi tăng dần đến hệ dung môi C: Me = 70:30 và sau cùng là Me. Dung dịch giải ly được hứng vào các lọ 50 ml, thực hiện SKLM các lọ và những lọ giống nhau được gom chung lại, cô quay thu hồi dung môi thu được các phân đoạn. Kết quả là sắc ký cột trên cao (3).2 thu được 3 phân đoạn ký hiệu từ (3).2.1 đến (3).2.3 (20,1 mg, 97,7 mg; 278,3 mg). Riêng phân đoạn (3).2.2 được sắc ký cột nhiều lần bằng hệ dung môi giải ly C: Me:CH3COOH = 90:10:0.5 thu được hợp chất tinh khiết VK01 (72 mg).
Phân đoạn (3).4: Phân đoạn (3).4 (112,5 mg) được tiến hành sắc ký cột silica gel pha thuận, giải ly với hệ dung môi C: Me: CH3COOH = 95:5:0.5 và sau cùng là Me. Dung dịch giải ly được hứng vào các lọ 50 ml, thực hiện SKLM các lọ và những lo giống nhau được gom chung lại, cô quay thu hồi dung môi thu được các phân đoạn. Kết quả là sắc ký cột trên cao (3).4 thu được 3 phân đoạn ký hiệu từ (3).4.1 và (3).4.2 (37.9 mg, 68.1 mg). Phân đoạn (3).4.2 được sắc ký cột nhiều lần bằng hệ dung môi giải ly C: Me:CH3COOH = 90:10:0.5 thu được hợp chất tinh khiết VK05 (25 mg).
* Cao chloroform (1) + cao ethyl acetate (2)
Thực hiện sắc ký cột silica gel pha thuận trên cao (1+2) (1,78 g) ban đầu với hệ dung môi C: Me = 90:10 rồi tăng dần độ phân cực đến hệ dung môi C:Me
= 50:50 và sau cùng là Me. Dung dịch giải ly được hứng vào các lọ 50 ml, thực hiện SKLM các lọ và những lọ giống nhau được gom chung lại, cô quay thu hồi dung môi thu được các phân đoạn. Kết quả là sắc ký cột trên cao (1+2) thu được 6 phân đoạn được ký hiệu từ (1+2).1 đến (1+2).6 (36,1 mg; 183,3 mg; 632,7 mg;
43,3 mg; 407,9 mg; 472,2 mg).
Phân đoạn (1+2).2
Phân đoạn (1+2).2 (183,3 mg) được tiến hành sắc ký cột silica gel pha thuận, giải ly với hệ dung môi C: Me = 95:5 rồi tăng dần đến hệ dung môi C:Me = 70:30 và sau cùng là Me. Dung dịch giải ly được hứng vào các lọ 50 ml, thực hiện SKLM các lọ và những lọ giống nhau được gom chung lại, cô quay thu hồi dung môi thu được các phân đoạn. Kết quả là sắc ký cột trên cao (1+2).2 thu được 4 phân đoạn ký hiệu từ (1+2).2.1 đến (1+2).2.4 (30,8 mg; 28,7 mg; 70,9 mg; 37,9 mg).
Phân đoạn (1+2).2.1 được tiến hành sắc ký cột siilca gel nhiều lần với hệ dung môi C: Me=95:5 thu được hợp chất tinh khiết VK04.
Hình 2.4. Quy trình phân tách thu nhận hợp chất VK04
* Xác định cấu trúc của các hợp chất : Các hợp chất sau khi phân tách được xác định cấu trúc tại phòng Phân tích Trung tâm, Trường Đại học Khoa học Tự nhiên Tp. Hồ Chí Minh.
* Xác định hoạt tính kháng tuyến trùng, kháng Phytophthora và nấm Fusarium của các hợp chất đã phân tách
Xác định hoạt tính kháng tuyến trùng: Hòa tan các hợp chất đã phân tách trong DMSO 10 %.
+ Đối với tuyến trùng tuổi 2 (IJ2): Hút 0,1 ml dung dịch này có nồng độ cuối đạt 2,5 mg/ml, 5 mg/ml, 10 mg/ml và 20 mg/ml cùng với 0,9 ml dịch tuyến trùng. Xác định tỷ lệ tử vong tuyến trùng sau 24 giờ.
+ Đối với trứng tuyến trùng: Hút 0,1 ml dung dịch này có nồng độ cuối đạt 2,5 mg/ml, 5 mg/ml, 10 mg/ml và 20 mg/ml cùng với 0,9 ml dịch trứng tuyến trùng. Xác định tỷ lệ nở của trứng tuyến trùng sau 3 ngày.
Xác định hoạt tính kháng Phytophthora và Fusarium: Hòa tan các hợp chất đã phân tách trong DMSO 10 %, tẩm lên đĩa giấy vô trùng (đường kính 1,2 cm) cách tâm đĩa 3 cm với các dãy nồng độ khảo sát 2,5 mg/ml, 5 mg/ml, 10 mg/ml và 20 mg/ml. Cấy nấm (đường kính 1cm) vào giữa đĩa. Xác định bán kính tản nấm sau 7 ngày và tính hiệu suất đối kháng với nấm bệnh.
2.2.3. Bước đầu tạo chế phẩm vi sinh phòng trừ nấm và tuyến trùng từ các chủng vi khuẩn tuyển chọn
Thí nghiệm 9:Sản xuất chế phẩm vi sinh phòng trừ nấm và tuyến trùng từ các chủng vi khuẩn tuyển chọn.
*Thời gian và địa điểm nghiên cứu: Nghiên cứu được thực hiện từ tháng 01/2020- 10/2020 tại phòng Công nghệ vi sinh, Viện CNSH&MT và phòng Công nghệ vi sinh, Bộ môn Sinh học, trường ĐH Tây Nguyên.
*Đối tượng nghiên cứu: chủng RB.DS29 kháng Phytophthora capsici, chủng RB.CJ41 kháng nấm Fusarium oxysporum và chủng RB.EK7 kháng tuyến trùng Meloidogyne sp. đã được định danh tại thí nghiệm 4.
* Chuẩn bị giống cấp 1: Cấy vi khuẩn từ ống giống vào bình tam giác có chứa sẵn 100 ml môi trường đã được hấp khử trùng ở 121oC trong 15 phút. Nuôi vi khuẩn trên máy lắc với thời gian 24 giờ, tốc độ 150 vòng/phút.
* Chuẩn bị giống cấp 2: giống cấp 1 được cấy vào bình tam giác 1000 ml chứa 400 ml môi trường, tỷ lệ 1% giống cấp 1.
* Lên men trong bioreactor được thực hiện dựa trên các thông số về môi trường, pH, thời gian, nhiệt độ đã được khảo sát ở thí nghiệm 5. Quá trình lên men được khuấy liên tục và thổi khí cưỡng bức. Trong quá trình lên men có thể dùng phá bọt. Dung dịch vi khuẩn được nuôi cấy trong bioreactor sử dụng làm chế phẩm cùng các vật liệu phụ gia khác nhau.
- Tỷ lệ phối trộn phụ gia và dịch vi khuẩn: 150 ml/kg phụ gia.
- Phơi khô trong mát không có ánh sáng chiếu trực tiếp vào khối cơ chất, thông thoáng khí, không quá ẩm thấp. Thường xuyên đảo trộn đến khi khối cơ chất đạt khoảng 10 % ẩm độ, tiến hành thu mẫu.
Các nghiệm thức phối trộn phụ gia:
+ Nghiệm thức 1: Cao lanh trắng
+ Nghiệm thức 2: Talc
+ Nghiệm thức 3: Lactose
+ Nghiệm thức 4: Bột mì
+ Nghiệm thức 5: Cám gạo
+ Nghiệm thức 6: Hỗn hợp cao lanh trắng + Talc + Lactose + Bột mì + Cám gạo (lượng phụ gia bằng nhau của các loại).
Chỉ tiêu theo dõi:
- Xác định mật độ vi khuẩn theo thời gian 06 tháng, một tháng kiểm tra 1 lần
- Đánh giá hiệu suất đối kháng Phytophthora, Fusarium và tỷ lệ tử vong tuyến trùng của chế phẩm vi khuẩn vùng rễ được thực hiện theo thí nghiệm 2.
2.2.4. Phương pháp xử lý số liệu
Các số liệu được xử lý phần mềm Microsoft Office Excel và phần mềm xử lý thống kê SAS (Statistical Analysis Systems) phiên bản 9.2 dùng cho Windows bằng phương pháp phân tích phương sai (ANOVA) 1 nhân tố sử dụng phép kiểm định Duncan.
CHƯƠNG 3 KẾT QUẢ VÀ THẢO LUẬN
3.1. Tuyển chọn các chủng vi khuẩn phân lập từ vùng rễ cây hồ tiêu tại Tây Nguyên, định danh các chủng có tiềm năng kháng Phytophthora, Fusarium và kháng tuyến trùng Meloidogyne gây bệnh rễ trên cây hồ tiêu tại Tây Nguyên
Luận án đã phân lập và mô tả hình thái 269 chủng vi khuẩn vùng rễ trong đó Đắk Lắk 120 chủng, Gia Lai 72 chủng và Đắk Nông 77 chủng (Phụ lục 1). Các chủng chủ yếu được phân lập tại vùng rễ của tiêu Vĩnh Linh trên nền đất đỏ bazan và được sử dụng làm vật liệu cho các nghiên cứu tuyển chọn tiếp theo.
3.1.1. Tuyển chọn các chủng vi khuẩn vùng rễ cây hồ tiêu có tiềm năng kháng Phytophthora, Fusarium, tuyến trùng Meloidogyne gây bệnh rễ ở cây hồ tiêu trong điều kiện in vitro
3.1.1.1. Tuyển chọn các chủng vi khuẩn vùng rễ cây hồ tiêu có tiềm năng kháng Phytophthora capsici
* Trong điều kiện in vitro
Các chủng vi khuẩn phân lập từ vùng rễ cây hồ tiêu tại ba tỉnh Tây Nguyên được nuôi cấy trên môi trường PGA cùng với Phytophthora nhằm tuyển chọn các chủng vi khuẩn vùng rễ có hoạt tính kháng nấm trong điều kiện in vitro. Khả năng đối kháng của các chủng vi khuẩn được đánh giá thông qua hiệu suất đối kháng nấm bệnh Phytophthora capsici.
Hình 3.1 Khả năng kháng Phytophthora của một số chủng vi khuẩn sau 7 ngày
Từ 269 chủng vi khuẩn phân lập từ vùng rễ của cây hồ tiêu, nghiên cứu đã ghi nhận được 27 chủng có khả năng kháng Phytophthora với hiệu suất đối kháng (%)
cao đạt từ 44,33-65,33% (bảng 3.1.) trong đó có 7 chủng với hiệu suất đối kháng Phytophthora cao nhất bao gồm RB.BH15, RB.EK2, RB.CP15, RB.CJ35 đều đạt 62,67%, RB.CS1 đạt 63%, RB.EK4 đạt 64,33% và RB. DS29 đạt 65,33% (hình 3.1).
Dưới kính hiển vi, hệ sợi của Phytophyhora phát triển kém, bị đứt gãy, vi khuẩn vùng rễ cạnh tranh chất dinh dưỡng trên môi trường thạch làm bào tử nấm bệnh có kích thức nhỏ hơn so với đối chứng (hình 3.2). Nhìn chung hiệu suất đối kháng với Phytophthora của các chủng trong nghiên cứu thấp hơn nghiên cứu của Irabor và Mmbaga (2017). Kết quả nghiên cứu đã tuyển chọn được 7 chủng có khả năng kháng Phytophthora capsici thuộc 3 chi Serratia (B17B), Enterobacter và Bacillus (IMC8, Y, Ps, Psl và Prt) từ 60,89% - 77,55% trên môi trường LB [135]. Tương tự, Anith và cộng sự (2003) đã phân lập được 64 chủng vi khuẩn có hoạt tính kháng Phytophthora capsici khoảng 7,1% - 86,11% [136]. Trong đó, chủng PN-026 có hoạt tính kháng nấm mạnh nhất đạt 86,11%. Tuy nhiên, kết quả nghiên cứu của chúng tôi cao hơn so với nghiên cứu của Ann (2012) đã ghi nhận vi khuẩn Bacillus atrophaeus phân lập từ rễ cây hồ tiêu cho hiệu quả ức chế nấm 32,7% [137].
Bảng 3.1. Hiệu suất đối kháng nấm bệnh của các chủng vi khuẩn phân lập từ vùng rễ cây hồ tiêu tại 3 tỉnh Tây Nguyên
Chủng | RTB(cm) | HSĐK (%) | TT | Chủng | RTB(cm) | HSĐK (%) | |
1 | RB.CK5 | 2,00 | 50,00 ±0,00h-j | 16 | RB.CS1 | 1,48 | 63,00±0,00a-c |
2 | RB.CK21 | 1,85 | 53,67±1,15g-i | 17 | RB.CS14 | 1,67 | 58,33±2,89d-f |
3 | RB.CK34 | 1,73 | 56,67±2,89e-g | 18 | RB.CP15 | 1,49 | 62,67±4,04a-d |
4 | RB.CK35 | 2,00 | 50,00±0,00i-h | 19 | RB.CJ8 | 1,67 | 58,33±2,89d-f |
5 | RB.BM5 | 2,09 | 47,67±2,52jk | 20 | RB.CJ10 | 2,03 | 49,33±1,15ij |
6 | RB.BM18 | 1,83 | 54,33±1,15f-h | 21 | RB.CJ12 | 1,52 | 62,00±1,73a-d |
7 | RB.BM19 | 2,23 | 44,33±1,15kl | 22 | RB.CJ14 | 1,99 | 50,33±2,52h-j |
8 | RB.BH11 | 1,63 | 59,33±4,04b-e | 23 | RB.CJ20 | 1,52 | 62,00±1,73a-d |
9 | RB.BH15 | 1,49 | 62,67±1,73a-d | 24 | RB.CJ27 | 1,52 | 62,00±1,15a-d |
10 | RB.EK2 | 1,49 | 62,67±2,52a-d | 25 | RB.CJ35 | 1,45 | 63,67±1,15ab |
11 | RB.EK4 | 1,43 | 64,33±4,04a | 26 | RB.DS28 | 2,29 | 42,67±2,52l |
12 | RB.EK5 | 1,65 | 58,67±1,15c-f | 27 | RB.DS29 | 1,39 | 65,33±2,52a |
13 | RB.EK7 | 1,56 | 61,00±1,73a-e | 28 | ĐC | 4,00 | - |
14 | RB.EK9 | 1,63 | 59,33±1,15bc-e | P | ** | ||
15 | RB.EK13 | 2,00 | 50,00±1,15i-h | CV% | 4,40 |
Có thể bạn quan tâm!
-
Phương Pháp Tuyển Chọn Các Chủng Vi Khuẩn Phân Lập Từ Vùng Rễ Cây Hồ Tiêu Tại Tây Nguyên, Định Danh Các Chủng Có Tiềm Năng Kháng Phytophthora, Fusarium -
Sơ Đồ Bố Trí Thí Nghiệm Tuyển Chọn Chủng Vi Sinh Vật Vùng Rễ Có Khả Năng Kháng Nấm Fusarium Trên Cây Hồ Tiêu Con Trong Điều Kiện Vườn Ươm -
Chương Trình Pha Động Trên Cột C18 -
Hiệu Quả Kháng Phytophthora Capsici Trên Đoạn Thân Hồ Tiêu -
Ảnh Hưởng Của Chủng Vi Khuẩn Đến Sinh Trưởng Rễ Của Cây Hồ Tiêu Sau 90 Ngày Lây Nhiễm Phytophthora -
Ảnh Hưởng Của Chủng Vi Khuẩn Đến Một Số Chỉ Tiêu Sinh Trưởng Và Kháng Bệnh Của Cây Hồ Tiêu Sau 120 Ngày Lây Nhiễm Nấm Fusarium
Xem toàn bộ 224 trang tài liệu này.
Ghi chú: R: Bán kính tản Phytophthora cấy trên đĩa đối kháng; ** Khác biệt có ý nghĩa thống kê ở mức p<0,01, các chữ cái giống nhau trên cùng một cột thể hiện sự khác biệt không có ý nghĩa thống kê theo trắc nghiệm phân hạng Duncan’s Multiple Rang Test.
Nhìn chung, trong 7 chủng vi khuẩn vùng rễ tuyển chọn với hoạt tính kháng Phytophthora cao nhất có 03 chủng phân lập tại huyện Buôn Hồ (RB.BH15) và huyện EaKar (RB.EK2 và RB.EK4) của tỉnh Đắk Lắk, 02 chủng phân lập tại huyện Cư Jut (RB.CJ35) và huyện Đắk Song (RB.DS29) của tỉnh Đắk Nông, 02 chủng phân lập tại huyện Chư Pưh (RB.CP15) và huyện Chư Sê (RB.CS1) của tỉnh Gia Lai. Đây là những huyện trồng hồ tiêu trọng điểm của 3 tỉnh Tây Nguyên, đặc biệt các huyện Đắk Song (Đắk Nông) và huyện Chư Sê, Chư Pưh (Gia Lai) được xem là thủ phủ hồ tiêu của Tây Nguyên. Tuy nhiên, đây cũng là những huyện có diện tích hồ tiêu nhiễm bệnh chết nhanh chết chậm cao ở Tây Nguyên.

Hình 3.2. Tác động của vi khuẩn vùng rễ đến hệ sợi Phytophthora
Trong điều kiện in vivo (trên đoạn thân hồ tiêu)
Đoạn thân hồ tiêu có chiều dài 8 cm (chứa một đốt thân) được xử lý với chủng vi khuẩn vùng rễ đã tuyển chọn từ thí nghiệm đánh giá hoạt tính kháng nấm trong điều kiện in vitro bao gồm RB.DS29, RB.BH15, RB.EK2, RB.CJ35, RB.CS1, RB.CP15, RB.EK4
và lây nhiễm với nấm bệnh Phytophthora để xác định chiều dài đoạn thân bị nấm xâm lấn nhằm tuyển chọn chủng vi khuẩn vùng rễ có hoạt tính kháng nấm bệnh cao trong điều kiện in vivo. Kết quả ghi nhận ở bảng 3.2 và hình 3.3 cho thấy, sự khác biệt về chiều dài đoạn thân bị nấm xâm lấn giữa các nghiệm thức có ý nghĩa thống kê ở mức p<0,01. Trong các nghiệm thức xử lý với các chủng vi khuẩn, chiều dài đoạn thân bị nấm xâm lấn có sự khác biệt về mặt thống kê giữa chủng RB.DS29 với các chủng RB.CS1, RB.CP15 và RB.EK4. Cụ thể: gấp 1,27 lần so với chủng RB.CS1, gấp 1,09 lần chủng RB.CP15 và 1,07 lần chủng RB.EK4. Tuy nhiên, chiều dài đoạn thân bị nấm xâm lấn






